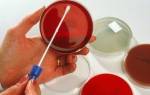

Форма выпуска Трихопола и его аналоги
Трихопол выпускают в различных лекарственных формах. Препарат применяют перорально и местно, оказывая двойное воздействие на патогены – изнутри и снаружи.
Таблетки белого цвета с легким желтоватым оттенком – основная форма выпуска лекарства, но также есть и другие:
- гель и крем для местного использования;
- свечи и таблетки вагинальные;
- порошок для изготовления лекарственных растворов, применяемых для внутривенных инъекций.
Аналоги препарата Трихопол, выпускаемые фармацевтической промышленностью, следующие:
- Медазол;
- Орвагил;
- Камезол;
- Флагил;
- Розамет;
- Трихазол;
- Метроксан;
- Арилин;
- Нидазол;
- Клион;
- Зоацид;
- Метроксан.
Во все эти препараты входит метронидазол как активное вещество.
Отзывы
Александра, 27 лет, Нижний Новгород
«От воспаления придатков помог только Трихопол. До него успела попробовать несколько препаратов, но ни один не оказался таким же эффективным. Но самим принимать его не советую, лучше сначала проконсультироваться с врачом».
Ирина, 19 лет, Москва
«Гинеколог прописала Трихопол от воспаления. Помогло быстро и эффективно, несмотря на незначительные побочные эффекты».
Олеся, 24 года, Казань
«Воспаление придатков вылечила Трихополом, но беспокоили побочные эффекты — появилась аллергия. В следующий раз, если будет нужно, попрошу у врача прописать что-то другое».
Фармакологическое действие и фармококинетика
Активное вещество Трихопола – метронидазол – это производное 5-нитроимидазола, обладающее антибактериальным, а также противопротозойным эффектом. Он губительно действует на аэробные и анаэробные бактерии и протисты, повреждает их ДНК, приостанавливая в них производство нуклеиновых кислот. К метронидазолу восприимчивы трихомонады, фузобактерии, гарднереллы, амебы, лямблии, клостридии, балантидии.
Препарат достаточно быстро попадает из желудка в кровь, равномерно распределяется по организму и проникает с током крови во все органы и ткани:
- кожу;
- слюну;
- сперму;
- желчь;
- печень;
- головной мозг;
- вагинальный секрет;
- спинномозговую жидкость;
- почки;
- легкие.
В них концентрация действующего вещества достигает максимального значения через 1,5-3 ч. (в зависимости от принимаемой дозы лекарства). Находящаяся в желудке пища уменьшает скорость проникновения метронидазола в кровоток. За метаболизм препарата в значительной степени ответственна печень, в которой преобразуется 30-60% лекарства. Образующиеся при этом метаболиты обладают тем же лекарственным действием, что и основное вещество. Период их полувыведения занимает 6-8 ч., при тяжелых болезнях печени он может возрастать. Выводится препарат почками (до 80%) и через кишечник (до 15%).
Противопоказания
Занимаюсь обнаружением и лечением паразитов уже много лет. С уверенностью могу сказать, что паразитами заражены практически все. Просто большинство из них крайне трудно обнаружимы. Они могут быть где угодно — в крови, кишечнике, легких, сердце, мозге. Паразиты в буквальном смысле пожирают вас изнутри, заодно отравляя организм. В итоге, появляются многочисленные проблемы со здоровьем, сокращающие жизнь на 15-25 лет.
Основная ошибка — затягивание! Чем раньше начать выводить паразитов, тем лучше. Если же говорить о лекарствах, то тут всё проблематично. На сегодняшний день существует только один действительно эффективный антипаразитный комплекс, это Toximin . Он уничтожает и выметает из организма всех известных паразитов — от головного мозга и сердца до печени и кишечника. На такое не способен больше ни один из существующих сегодня препаратов.
В рамках Федеральной программы, при подаче заявки до 12 октября . (включительно) каждый житель РФ и СНГ может получить одну упаковку Toximin БЕСПЛАТНО!
Перед началом лечения Трихополом необходимо изучить аннотацию, чтобы убедиться в отсутствии противопоказаний.
Основные ограничения для приема Трихопола:
- тяжелые патологии почек, печени;
- лейкопения, заболевания органов кроветворной системы;
- нарушения в работе центральной нервной системы;
- атаксия;
- астма;
- экзема;
- опухоли, некоторые болезни головного мозга;
- повышенная чувствительность, непереносимость составляющих лекарственного средства.
Как нужно принимать Трихопол в таблетках
Доза и схема приема лекарства зависит от вида женского заболевания. Например:
- При уреаплазмозе, хламидиозе и трихоплазмозе препарат принимают внутрь после приема пищи по 2 табл. по утрам и вечерам или 3 раза в день по 1 табл. на протяжении недели.
- При цистите, уретрите и эндометриозе таблетки Трихопола пьют в тех же дозах, но уже 10 дней подряд.
- Молочницу и вагинит лечат на протяжении 5-10 суток, принимая по 2 табл. 2 раза каждый день.
Это стандартная схема применения этого препарата при гинекологических заболеваниях, которая, впрочем, может меняться в зависимости от развития заболевания, возраста, общего состояния больной женщины и ее индивидуальной реакции на проводимое лечение. Решение об изменении схемы терапии принимает лечащий врач пациентки.
Лечение дополняют вагинальными свечами с Трихополом, которые меняют каждый день на протяжении всего курса лечения. Одновременно проводят профилактическое лечение и полового партнера пациентки.
По окончании первого курса приема медпрепарата делают перерыв на 4-6 недель, а затем проводят повторный курс. До начала и после завершения терапии сдают анализ крови на общий объем лейкоцитов в крови и лейкоцитарную формулу.
Общие принципы лечения аднексита антибиотиками
Перед тем как назначить таблетки или уколы при воспалении придатков, врачу нужно определить тип возбудителя. Для этого на бактериальный посев берется секрет. По результатам выявляется патогенная микрофлора, после чего назначается антибиотик из соответствующей группы.
Врачами назначаются препараты из следующих групп:
- тетрациклины;
- фторхинолоны;
- макролиды;
- цефалоспорины;
- пенициллины;
- аминогликозиды;
- нитроимидазолы;
- карбапенемы.
Если путем лабораторных анализов тип возбудителя установить не удалось, назначаются антибиотики широкого спектра действия. Тот же подход эффективен, когда произошло заражение сразу несколькими видами патогенной микрофлоры.
При остром аднексите всегда назначаются антибактериальные средства. Если заболевание хроническое, антибиотики в гинекологии при воспалении придатков назначаются лишь на стадии обострения. Симптомы у пациенток наблюдаются те же, что и в случае с острым воспалением яичников.
Использование Трихопола при бактериальном вагинозе
Это одно из самых распространенных гинекологических заболеваний. Бактериальным вагинозом называется дисбиоз влагалищной флоры, вызываемый подавлением роста лактобактерий, составляющих более 95% здоровой микрофлоры и сильным увеличением условно-патогенных бактерий, в основном гарднерелл.
Лечение этого заболевания проводят в 2 этапа. Сначала уничтожают размножившиеся условно-патогенные бактерии, для чего и прописывают Трихопол.
Принимают Трихопол при бактериальном вагинозе:
- однократно 8 табл. на протяжении только 1 суток;
- по 2 табл. 2 раза в день, но уже на протяжении 1 недели.
Опасные последствия болезни
Хотя заражение Trichomonas vaginalis неопасно для жизни, без лечения инфекция может привести к серьезным осложнениям. Чем опасен трихомониаз?
Основные осложнения заболевания касаются мочевыделительной и репродуктивных функций:
Любое воспаление рано или поздно приводит к повреждению и рубцовым изменениям в тканях. Именно поэтому сужение (стриктура) просвета уретры – одно из самых распространенных осложнений ЗППП и трихомониаза в частности.
Из-за анатомических особенностей чаще встречается у мужчин и характеризуется:
- дискомфортом внизу живота;
- чувством неполного опорожнения мочевого пузыря;
- резями при мочеиспускании;
- иногда — примесью крови в моче.
Цистит – развитие воспаления мочевого пузыря – также часто диагностируется при трихомонозе. Больше подвержены этому заболеванию женщины.
Среди характерной симптоматики:
- боли острого, режущего, покалывающего характера в животе;
- мучительные позывы к мочеиспусканию;
- общие проявления интоксикации – лихорадка, слабость, ухудшение аппетита и утомляемость.
Если трихомонады проникают в верхние отделы половой системы пациентки, развивается специфическое воспалительное поражение матки с придатками.
Оно может проявляться:
Часто на фоне воспаления происходит деформация и формирование спаек в области маточных труб, а их проходимость нарушается. Печальный итог – бесплодие.
Чем грозит трихомониаз сильному полу? В случае простатита инфекция «перекидывается» на предстательную железу мужчины.
Это осложнение проявляется:
- жжением, дискомфортом, тянущими болями в области промежности и заднего прохода;
- выделениями из уретры;
- прожилками крови в эякуляте;
- частым болезненным мочеиспусканием;
- ложными позывами.
Важно! Главная опасность хронического воспаления простаты заключается в снижении сексуального влечения у мужчины, а также в нарастающих проблемах с эрекцией вплоть до полной импотенции.
Воспаление яичка с придатком (орхоэпидидимит) при трихомонозе встречается редко, но может привести к такому грозному осложнению, как мужское бесплодие.
Основные симптомы патологии:
- боли, чувство тяжести в области яичка;
- отек мошонки;
- повышение Т° тела.
Чтобы не допустить серьезных проблем со здоровьем, важно вовремя начать терапевтические мероприятия. Чем лечат трихомониаз у женщин и мужчин – давайте разбираться.
Кому и когда не назначают Трихопол
Не прописывают это средство при индивидуальной восприимчивости к метронидазолу или прочим его составляющим, а также при травмах головы и следующих болезнях:
- лейкопении;
- недостаточности печени (в больших дозах);
- патологиях и органических поражениях мозга и ЦНС (в том числе при эпилепсии);
- заболеваниях крови.
Не назначают Трихопол и детям, не достигшим 3 лет. Беременным женщинам в 1 триместре и в период грудного вскармливания ребенка он также противопоказан, так как метронидазол может проникать к эмбриону через плацентарный барьер, а после рождения малыша и в грудное молоко. Прописывают его только при крайней необходимости, если срочно нужно лечить будущую мать. В этом случае жизнь женщины важнее, чем возможный риск развития осложнений у плода. Во 2 и 3 триместре беременности лекарство назначают, но с осторожностью.
Вагинальные гели и кремы, свечи и таблетки с метронидазолом в период вынашивания ребенка и вскармливания его грудью не противопоказаны, поскольку из этих фармацевтических форм он в общий кровоток не всасывается и не проникает в матку или грудное молоко.
Общие сведения
Согласно последним статистическим данным, трихомониаз (или, как еще говорят, трихомоноз) «обогнал» по распространенности гонорею и является самой диагностируемой венерической инфекцией.
Ее возбудитель – Trichomonas vaginalis – представитель биологической группы простейших и по строению является одноклеточным организмом.
Он обитает в мочеполовых путях больных мужчин и женщин и передается:
- половым путем (в 99% случаев);
- при тесных бытовых контактах – крайне редко, поскольку трихомонады крайне неустойчивы во внешней среде;
- ребенку от матери в момент родов (подробней читайте тут).
Болезнь относится к высокозаразным: даже при единичном половом акте риск инфицирования составляет 60-70 для мужчин и 80-100% для женщин. У большинства представителей сильного пола это ЗППП протекает бессимптомно, поэтому именно они чаще всего становятся носителями трихомонады.
Это интересно. По оценкам ВОЗ, трихомониазом страдает каждый десятый житель нашей планеты. Многие даже не подозревают об этом. Вы не из их числа?
Побочные эффекты лекарства
У Трихопола, как и у многих лекарственных средств, есть и побочные действия.
Например, ЖКТ может реагировать на него:
- понижением аппетита;
- болью в эпигастральной зоне;
- тошнотой и последующей рвотой;
- кишечными коликами;
- поносами и запорами;
- «металлическим» привкусом и сухостью в ротовой полости;
- глосситом и стоматитом.
Гораздо реже развиваются желтуха, гепатит и панкреатит.
Лекарственное взаимодействие
Прежде чем приступать к лечению какого-либо заболевания, нужно четко знать, с какими лекарствами допустимо сочетать препарат, а с какими категорически запрещено.
- взаимодействие данного медикамента с Амоксициллином недопустимо в том случае, когда пациенту не исполнилось 16 лет;
- если параллельно с Метронидазолом использовать антацидные средства, в которых содержится гидроксид алюминия, то эффективность лечения уменьшится;
- на период лечения, чтобы избежать побочных эффектов, стоит отказаться от спиртных напитков, так как этанол окисляется данным препаратом, вследствие чего возникает тошнота, рвота, головные боли и неврологические отклонения;
- при совместном применении с непрямыми антикоагулянтами, их воздействие возрастает;
- если лечиться Метронидазолом и Лансопразолом одновременно, то может возникнуть стоматит, глоссит, а также язык приобретет темный окрас;
- нельзя данный медикамент применять вместе с Карбамазепином, так как лечение способно закончиться токсическим отравлением;
- совместное лечение с лития карбонатом приведет к развитию интоксикации;
- взаимодействие Метронидазола с Преднизолоном повышают метаболизм в органах, тем самым снижая результативность лечения;
- может развиться дистония, если лечение проводить совместно с хлорамином;
- запрещено во время лечения Метронидазолом принимать Дисульфирам, потому что может возникнуть острый психоз.
Если у пациента были обнаружены венерические либо мочеполовые заболевания, то обязательно требуется лечение обоих половых партнеров. Во время терапии следует отказаться от половых контактов.
Передозировка и особенности использования Трихопола
В случае употребления увеличенных доз лекарства вырастает вероятность появления тошноты, атаксии, рвоты, анорексии, судорог и парестезий. При отравлении этим медикаментом нужно сделать промывание желудка и принять несколько таблеток активированного угля.
В период терапии Трихополом категорически нельзя принимать алкоголь во всяком виде, но особенно крепкий. Сочетание этих веществ провоцирует:
- боль в голове;
- схваткоподобные боли в кишечнике;
- сильную тошноту;
- гиперемию кожи.
Рекомендуется воздержаться от секса в период терапии трихомонадного вагинита и уретрита. В период длительного курса терапии нужно контролировать состав крови. Тем, кто работает с автотранспортом и точными или опасными механизмами, нужно найти какой-то другой препарат, поскольку побочные эффекты Трихопола в виде головокружений, галлюцинаций, судорог и спутанности сознания могут значительно нарушить процесс ответственной работы.
Показания к применению
Медикамент назначается при:
- протозойных инфекциях: внекишечном и кишечном амебиазе, балантидиазе, трихомонадном вагините, гиардиазисе, трихомониазе, лейшманиозе, трихомонадном уретрите;
- гастрите или язве двенадцатиперстной кишки, обусловленных наличием Helicobacter pylori;
- лучевой терапии онкологических больных;
- сепсисе;
- алкоголизме;
- инфекциях суставов и костей, абсцессе мозга, менингите, пневмонии, бактериальном эндокардите, абсцессе легких, эмпиеме;
- псевдомембранозном колите, вызванном антибиотикотерапией;
- проведении гинекологических операций, аппендэктомии, хирургических вмешательств в околоректальной области и на ободочной кишке (для профилактики осложнений);
- инфекциях мягких тканей и кожи, брюшной полости (абсцесс печени, перитонит), органов таза (эндометрит, абсцесс яичников и фаллопиевых труб, эндомиометрит).
Как Трихопол взаимодействует с другими препаратами
Одновременный прием Трихопола с Фенобарбиталом и Фенитоином не желателен, так как эти лекарства ускоряют выведение активного вещества и таким образом уменьшают концентрацию последнего в сыворотке крови.
Не назначают с Трихополом и Циметидин. Это соединение тормозит его метаболизм, что повышает концентрацию метронидазола в крови и повышает вероятность появления побочных явлений. Дисульфирам назначают только спустя 2 недели после приема Трихопола, чтобы свести к минимуму развитие неврологических симптомов. Одновременный прием метронидазола и препаратов лития провоцирует накопление этого элемента в плазме и интоксикацию. В то же время прием сульфаниламидов и Трихопола увеличивает противомикробный эффект последнего.
Контрольные анализы – обязательны
В настоящее время выделяют два показателя «излеченности» от трихомоноза:
- клинический – полное исчезновение симптомов заболевания;
- этиологический – эрадикация возбудителя из организма.
Даже если клинические проявления болезни отсутствуют, пациенту обязательно нужно пройти контрольное обследование, чтобы убедиться в том, что трихомоноз полностью побежден. Как правило, дерматовенерологи рекомендуют повторно сдать биоматериал для проведения ПЦР или бакпосева.
Отрицательные результаты этих тестов с вероятностью почти 100% являются признаком того, что болезнь вылечена.